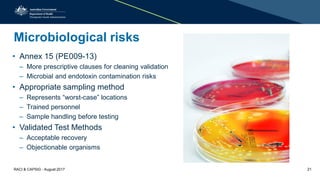
Microbiological risks
• Annex 15 (PE009-13)
– More prescriptive clauses for cleaning validation
– Microbial and endotoxin contamination risks
• Appropriate sampling method
– Represents “worst-case” locations
– Trained personnel
– Sample handling before testing
• Validated Test Methods
– Acceptable recovery
– Objectionable organisms
RACI & CAPSIG - August 2017 21

This document discusses cleaning validation requirements from a regulatory perspective. It provides an overview of key concepts in cleaning validation including establishing health-based exposure limits and determining maximum allowable carryover levels. A risk-based approach using bracketing and worst-case determination is recommended. Common deficiencies observed include inadequate hazard assessment, lack of justification for cleaning approaches, and failure to revalidate cleaning when processes change. International GMPs are incorporating guidelines for setting health-based exposure limits to ensure contamination risks are properly managed.